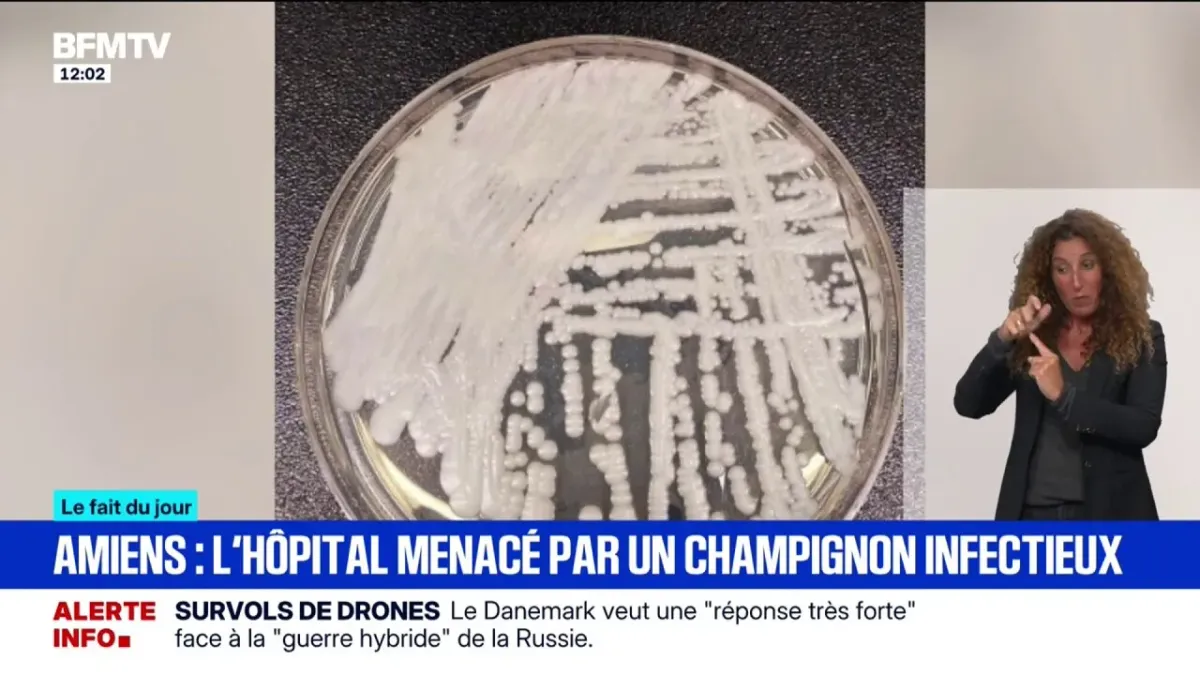

L'hôpital d'Amiens lutte contre un champignon infectieux résistant
Le champignon infectieux "Candidozyma auris" est considéré comme un agent pathogène prioritaire critique par l'OMS. Depuis le début de l'année, 26 cas ont été recensés à Amiens.
| Durée : 1:35